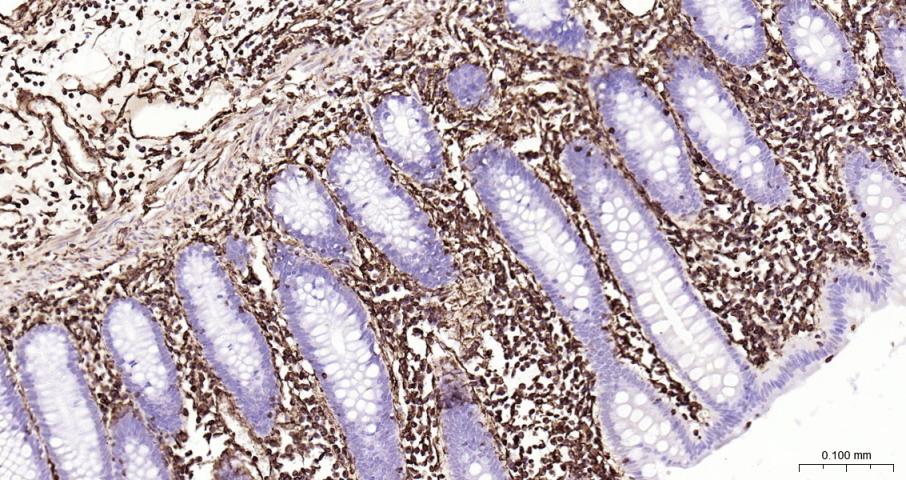
Vimentin Recombinant Rabbit mA

相关产品推荐更多 >

Integrin beta 1 Rabbit pAb, BF488 conjugated(bs-0486R-BF488)-100ul
¥2980
HSF1 Rabbit pAb, APC conjugated(bs-3757R-APC)-100ul
¥2980
RAC1+RAC2 Rabbit pAb, Biotin conjugated(bs-6154R-Bio)-100ul
¥2980
phospho-NMDAR2A (Tyr1325) Rabbit pAb, Pacific Blue conjugated(bs-3305R-PacificBlue)-100ul
¥2980
phospho-PRKCB (Thr642) Rabbit pAb, FITC conjugated(bs-5566R-FITC)-100ul
¥2980
万千商家帮你免费找货
0 人在求购买到急需产品
- 详细信息
- 技术资料
- 应用范围:
产品信息以Bioss网站为准
- 规格:
25ul/50ul/100ul
| 规格: | 25ul | 产品价格: | ¥800.0 |
|---|---|---|---|
| 规格: | 50ul | 产品价格: | ¥1400.0 |
| 规格: | 100ul | 产品价格: | ¥2500.0 |
| 产品编号 | bsm-33170R |
| 英文名称 | Vimentin Recombinant Rabbit mAb |
| 中文名称 | 波形蛋白重组兔单抗 |
| 英文别名 | FLJ36605; OTTHUMP00000019224; VIM; VIME_HUMAN; Vimentin. |
| 产品应用 | IHC-P=1:200-1000, IHC-F=1:200-1000, IF=1:200-1000, WB=1:1000-5000, Flow-Cyt=1μg/Test Not yet tested in other applications. |
| 交叉反应 | Human |
| 抗体来源 | Rabbit |
| 免疫原 | Recombinant human Vimentin Protein |
| 亚型 | IgG |
| 性状 | Liquid |
| 纯化方法 | affinity purified by Protein A |
| 克隆类型 | Recombinant |
| 理论分子量 | 53 kDa |
| 浓度 | 1mg/ml |
| 储存液 | 0.01M TBS (pH7.4) with 1% BSA, 0.02% Proclin300 and 50% Glycerol. |
| 研究领域 | Cancer > Tumor biomarkers Developmental Biology > Lineage specification > Ectoderm Neuroscience > Cell Type Marker > Neural Stem Cell marker Neuroscience > Neurology process > Neurogenesis Neuroscience > Neurology process > Neuroregeneration > Neuroregeneration Signal Transduction > Antibodies > vimentin Signal Transduction > Cytoskeleton / ECM > Cytoskeleton > Intermediate Filaments > Class III > Vimentin Stem Cells > Lineage Markers > Endoderm Stem Cells > Neural Stem Cells > Intracellular |
| 亚基 | Homopolymer assembled from elementary dimers. Interacts with HCV core protein. Interacts with LGSN and SYNM. Interacts (via rod region) with PLEC (via CH 1 domain) (By similarity). Interacts with SLC6A4. Interacts with STK33. Interacts with LARP6. Interacts with RAB8B (By similarity). |
| 亚细胞定位 | Cytoplasm. |
| 组织特异性 | Highly expressed in fibroblasts, somev expression in T- and B-lymphocytes, and little or no expression in Burkitt's lymphoma cell lines. Expressed in many hormone-independent mammary carcinoma cell lines. |
| 翻译后修饰 | Filament disassembly during mitosis is promoted by phosphorylation at Ser-55 as well as by nestin (By similarity). One of the most prominent phosphoproteins in various cells of mesenchymal origin. Phosphorylation is enhanced during cell division, at which time vimentin filaments are significantly reorganized. Phosphorylation by PKN1 inhibits the formation of filaments. Phosphorylated at Ser-56 by CDK5 during neutrophil secretion in the cytoplasm. Phosphorylated by STK33. |
| 相似性 | Belongs to the intermediate filament family. |
| 功能 | Vimentins are class-III intermediate filaments found in various non-epithelial cells, especially mesenchymal cells. Vimentin is attached to the nucleus, endoplasmic reticulum, and mitochondria, either laterally or terminally. Involved with LARP6 in the stabilization of type I collagen mRNAs for CO1A1 and CO1A2. |
| 保存条件 | Shipped at 4℃. Store at -20℃ for one year. Avoid repeated freeze/thaw cycles. |
| 注意事项 | This product as supplied is intended for research use only, not for use in human, therapeutic or diagnostic applications. |
| 背景资料 | This gene encodes a member of the intermediate filament family. Intermediate filamentents, along with microtubules and actin microfilaments, make up the cytoskeleton. The protein encoded by this gene is responsible for maintaining cell shape, integrity of the cytoplasm, and stabilizing cytoskeletal interactions. It is also involved in the immune response, and controls the transport of low-density lipoprotein (LDL)-derived cholesterol from a lysosome to the site of esterification. It functions as an organizer of a number of critical proteins involved in attachment, migration, and cell signaling. Mutations in this gene causes a dominant, pulverulent cataract.[provided by RefSeq, Jun 2009] |
| 应用 | 推荐稀释比例 |
| {IHC-P} | {1:200-1000} |
| {IHC-F} | {1:200-1000} |
| {IF} | {1:200-1000} |
| {WB} | {1:1000-5000} |
| {Flow-Cyt} | {1μg/Test} |

风险提示:丁香通仅作为第三方平台,为商家信息发布提供平台空间。用户咨询产品时请注意保护个人信息及财产安全,合理判断,谨慎选购商品,商家和用户对交易行为负责。对于医疗器械类产品,请先查证核实企业经营资质和医疗器械产品注册证情况。
 技术资料
技术资料暂无技术资料 索取技术资料





